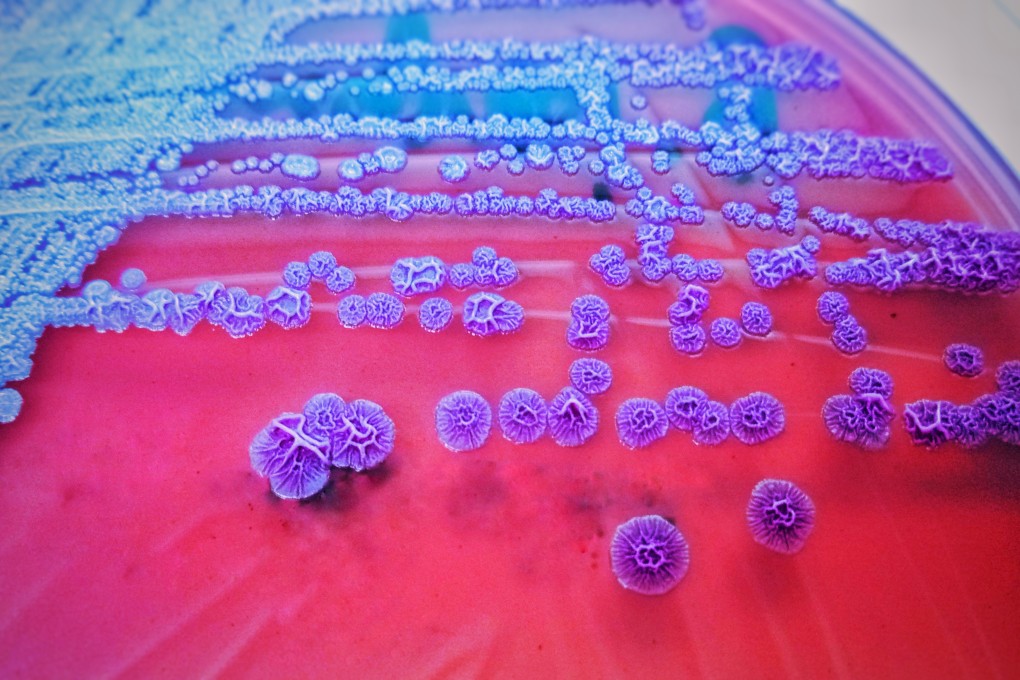
The authorities have closed their melioidosis investigation after finding Burkholderia pseudomallei bacteria in the soil above two reservoirs that serve the area where the bulk of infections were discovered. Photo: Shutterstock

Melioidosis outbreak in Hong Kong may have originated at reservoir in West Kowloon but water is safe, expert says
- Expert team still cannot say how it spread but highlighted several possibilities including bacterium entering reservoir through air vents
- We have to accept the disease has become endemic but there is no need to be too concerned, says expert
An abnormal spate of melioidosis, a fatal infectious disease, in Hong Kong might have originated from the bacterium found in the soil on top of a reservoir in West Kowloon after a government investigation found the DNA profiles highly identical.
Revealing the findings on Thursday, a top microbiologist leading the investigation said it was unknown how the bacterium had been passed on to the patients, stressing the city’s fresh water supply was still safe.
“The tests conducted on water samples collected from the reservoir in Shek Kip Mei so far all tested negative,” Professor Yuen Kwok-yung from the University of Hong Kong said. “All we know is that the DNA [of patients and soil samples] are almost the same, and the soil samples were collected on top of the reservoir.”

Caused by the bacterium Burkholderia pseudomallei, which is abundant in soil, especially moist clay, and muddy water, melioidosis is an infectious disease with symptoms including fever, headache, cough, chest pain, ulceration and localised pain or swelling.
A total of 34 melioidosis cases have been found in Hong Kong this year, considered as unusual compared with previous years, with 23 detected in the Sham Shui Po district. Seven patients have died of the disease.
Health authorities found that the cases in Sham Shui Po district were in the proximity of the Shek Kip Mei and Butterfly Valley reservoirs, and a construction site at Pak Tin Estate.
Among the 471 environmental samples obtained from the area, 38 of them contained the bacterium, with 32 being collected from the soil on top of the reservoirs. Four of the soil samples from the reservoir were genetically similar to the samples collected from the patients in the district.